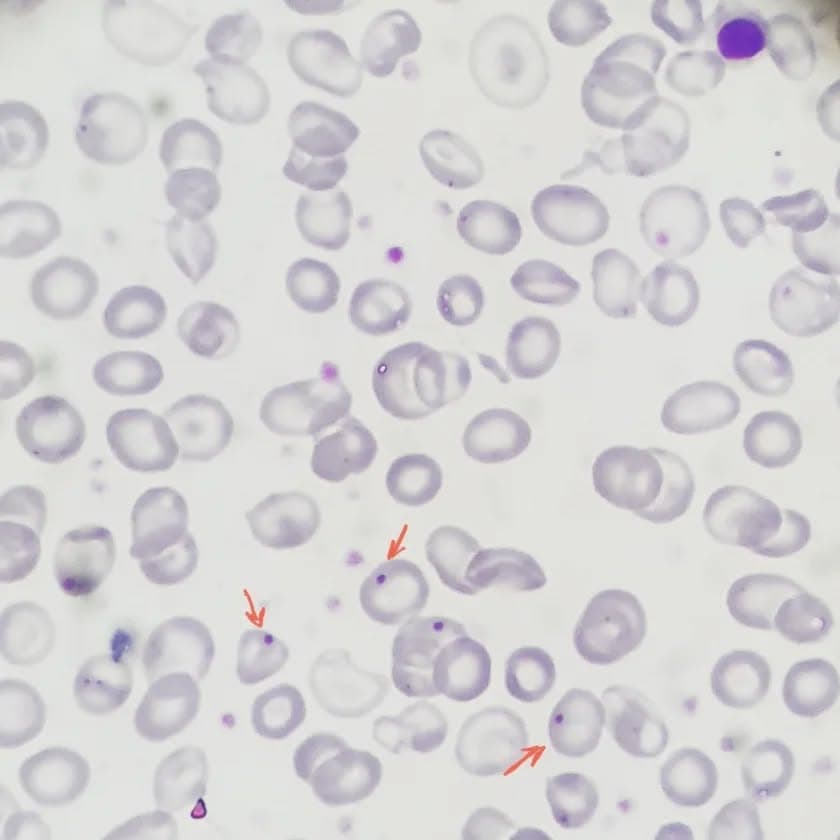
A case of beta thalassemia major who has undergone splenectomy.
On peripheral blood smear howell jolly bodies as well as many target cells are present as a consequence of splenectomy.

Back to Posts February 10, 2022
February 10, 2022
Photo 1 of 3
professionalcasebeta
Caption: A case of beta thalassemia major who has undergone splenectomy. On peripheral blood smear howell jolly bodies as well as many target cells are present as a consequence of splenectomy.